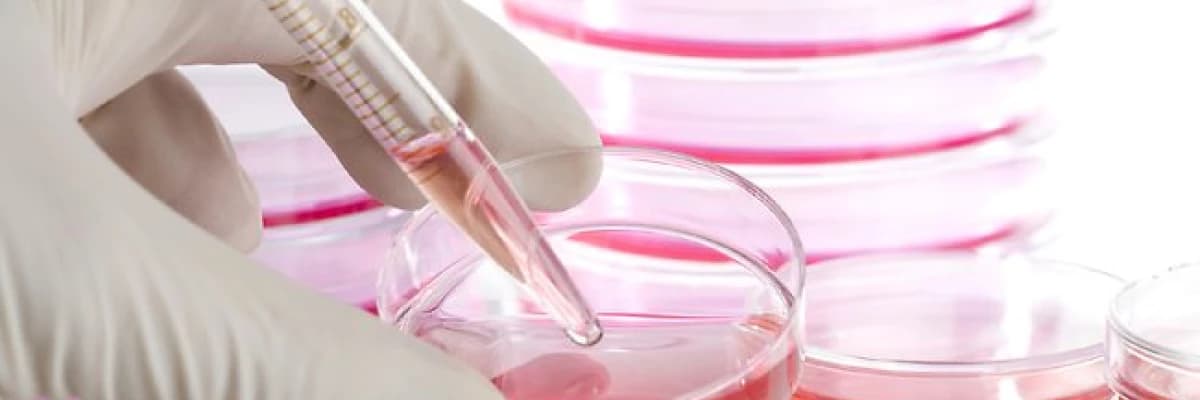
Kök hücre tedavileri

Kök hücre tedavileri

Kök hücrelerin hastalıkların tedavisinde kullanımı
Uzun zamandır yetişin kök hücre tedavileri, lösemi gibi bazı kan hastalıklarında başarıyla uygulanmaktadır. Son yıllarda, esas ümit vaad eden çalışmalar, hücre ölümüyle giden felç, bazı göz retina hastalıkları ve kalp krizi gibi birçok hastalığın tedavisinde kullanılmasıyla ilgilidir. Ancak bu konularda ciddi kontrollü ve uzun dönem izlemli çalışmalara ihtiyaç vardır. Daha az çalışılmakla birlikte cilt hastalıları, kısırlık, saç dökülmesi, diş tedavileri gibi birçok konuda deneysel çalışmalar bulunmaktadır. En çok çalışma yapılan bazı hastalık gruplarını aşağıda bulabilirsiniz.
Kök hücre ve kan hastalıkları
Hematopoietik Kök Hücre Transplantasyonu (HKHT) ağır aplastik anemi, lösemi ve diğer bazı maligniteleri olan hastaların tedavisi için kullanılan bir yöntemdir(1). Yetişkin hücrelerinin kullanımı, embriyo kök hücreleri gibi tartışmalı değildir; bir embriyonun yok edilmesi gerekmez, kişinin kendisinden alındığı için, kanser riski doku reddi gibi sorunlar çok daha az görülür.
Kök hücre ve felç tedavileri
Son yıllarda, travmatik omurilik yaralanmasının (OY) tedavisinde kök hücrelerin kullanımının umut vaad eden sonuçları vardır. nöral kök hücreler (sinirkök hücreleri) veya embriyonik kök hücreler (EKH) gibi nakil için kullanılabilecek değişik kaynak kök hücreler mevcuttur. OY tedavisinde kök hücrelerin potansiyel olarak kullanımı için deneysel ve klinik çalışmalar halen devam etmektedir. Nakil yapılarak sinir hücrelerinin tedavi olanağı geliştikçe, genellikle cerrahi girişim ile tedavi edilmeyen OY nöroşirürji alanına girecektir. Bu nedenle, kök hücre biyolojisi alanında nöroşirürjiyenlerin eğitimi gereklidir(2).
Yalnız kök hücre ile felç tedavisi en çok suhistimal edilen konulardan biridir. Lefkoşa Yakındoğu Üniversitesinden Nöroşirürji uzmanı sayın Erkan Kaptanoğlu yaptığı çalışmanın tartışma bölümünde bu konuya özellikle dikkat çekmiştir:
Birkaç yıl önce omuriliğin gerçek tamiri (rejenerasyon) imkansız olarak görülmekte idi. Günümüzde halen tatmin edici bir tedavi metodu bulunamamış olmakla birlikte, ne mutludur ki hücre, hayvan ve son zamanlardaki insan deney ve araştırmalarının sonuçları ümit vericidir.
Sınırlı sayıda yayınlanan Faz I çalışmaların sonucunda bildirilen tedavi metotlarının etkinliğini kanıtlamak için uzun süreli, vaka-kontrollü, randomize, kör, çok merkezli çalışmalara gereksinim duyulduğu belirtilmektedir. Aksi takdirde klinik araştırması yapılmamış ya da henüz tamamlanmamış bir metot, standart tedavi metodu olarak kabul edilemez.
Omurilik yaralanması sonucu felç olan hastalar ve aileleri bu ağır patoloji ve sakatlık ile ruhsal, sosyal, fiziksel ve maddi olarak mücadele etmek zorundalardır. Bazı bilim merkezleri kök hücrelerin her derde deva olduğunu bildirmektedir. İnternette ve medyada bu hücreleri ya da benzerlerini kullanarak hastaları belli bir ücret karşılığı iyileştirdiğini bildiren ilanlara rastlamak mümkündür. Omurilik yaralanmasında hastaları iyileştirdiğini reklam yolu ile duyuran kliniklerin bu konuda bilimsel yayın ya da bilimsel araştırmasına hiç rastlanmadığı göz önünde bulundurulmalıdır. Bu denemeler, tecrübeler ya da bilgiler, hastalar ve aileleri ile paylaşılmadan önce bilimsel, kanıta dayalı, ispatlanabilir ve tekrarlanabilir özellikleri ile bilimsel ortamlarda paylaşılmalı ve tartışılmalıdır(3).
Kök hücre ve körlük
Son yıllarda, kök hücreler, retinanın körlükle sonuçlanan bazı kalıtsal ve edinsel hastalıkları için tedavi umudu olmuştur. Son 10 yılda yapılan deneysel çalışmalar, retinadaki ileri düzeyde özelleşmiş hücre kayıplarının göz ve göz dışı kök hücre kaynaklarınca yerine konması ve işlevlerinin sürdürülmesinin olası olduğunu göstermiştir. Mezenkimal kök hücreler, etik problemlerin daha az olması ve kolay elde edilebilmeleri ile bu çalışmalarda tercih edilmektedir(4).
Kök hücre ve kalp krizi
Yapılan bir çok çalışmada nakil edilen kök hücrelerin, kardiyomiyosit(kalp kası hücresi) ve yeni damar oluşumunu sağladığı ve bunun ötesinde kardiyomiyositlerin kasılma fonksiyonu gösterdiği tespit edilmiştir(5).
İslamın kök hücreye bakışı
Bu konuda endişesi olan okurlarımız için, Marmara Üniversitesi İlahiyat Fakültesi Öğretim Üyesi, M. Saim Yeprem’in bir çalışmasına da yer vererek bu konuyu tamamlamak istiyorum.
Bu konu Doğrudan Kur'an ayetlerinde bulunamayacağına göre, Kur'an'ın bütününden çıkarılan "İslam'ın Temel Prensipleri Açısından Kök Hücre Çalışmaları" şeklinde ele alınarak mütalaa edilmesi en uygun yaklaşımdır. İnsanın başlangıcı "zigot" hali olduğundan, ister laboratuar ortamında olsun isterse ana rahminde bulunsun, kök hücre elde etmek maksadıyla embriyonun itlafına olumlu bakmak mümkün değildir. Ancak herhangi bir sebeple sonlandırılmış gebelik, düşük, kürtaj ve IVF'de implantasyon sonrası artan embriyolar gibi materyallerden bu maksatlarla yararlanılabilir. İslam, embriyonik kök hücre yerine yetişkin kök hücrelerinin, düşük veya ölü doğan bebeklerden elde edilen kök hücrelerin kullanılması gibi alternatif çalışmaları desteklemektedir. Bu daha az sorun getirecektir. Ancak kök hücre çalışmaları, bir hastalığı tedavi etmek veya önlemek gibi yüce maksatlar için kullanıldığı takdirde elbette bu müdahale İslam'ın da desteklediği ve tavsiye ettiği bir müdahale olarak kabul edilmelidir(6).
Kaynaklar:
1.Gamze AKBULUT, Hematopoietik Kök Hücre Transplantasyonu (HKHT)’nda Tıbbi Beslenme Tedavisi. International Journal of Hematology and Oncology 2013, Vol 23, Num 1 Page(s): 055-065.
2.Serdar KABATAŞ, Yang D. TENG.Omurilik Yaralanmasının Tedavisinde Nöral Kök Hücrenin Potansiyel Rolleri: Literatürün Gözden Geçirilmesi.
Turksih Neurosurgery. 2010, Volume 20, Number 2, Page(s) 103-110
3.Erkan KAPTANOĞLU,Yakındoğu Üniversitesi Tıp Fakültesi, Beyin ve Sinir Cerrahisi Kliniği, Lefkoşa, Kıbrıs
4. Gökhan ÖZGE, Güngör SOBACI, GATA Göz Hastalıkları A.D
5.Min JY, Sullivan MF, Yang Y, et al. Significant improvement of heart function by cotransplantation of human mesenchymal stem cells and fetal cardiomyocytes in postinfarcted pigs. Ann Thorac 2002; 74: 1568-75.
6.M. Saim YEPREM. Marmara Üniversitesi İlahiyat Fakültesi Öğretim Üyesi, İSTANBUL. An Islam Perspectıve On Stem Cell. Turkiye Klinikleri J Surg Med Sci 2006;2(43):87-90